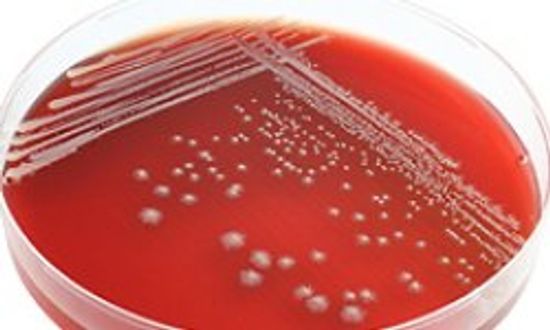
你能做青霉素过敏测试吗?＂class=

过敏
食物、动物皮屑和环境都是一些人过敏反应的原因。了解过敏的类型和治疗方法。
了解更多
春天也许很美丽,但对于过敏的人来说,这是一年中最难熬的时刻。这就是为什么它们依赖每天的花粉数量来缓解压力。
通过凯莉·惠特尼博士
一项新的研究表明,大约1018新利最新登入%自认为食物过敏的美国人实际上存在食物不耐受问题。那么有什么不同呢?
通过戴夫·鲁斯
你的身体从来没有被蜜蜂蛰过。但有一天,你被蜜蜂蛰伤后出现了过敏反应。怎么回事?
通过Jesslyn盾牌
这被称为口腔过敏综合征,是由于免疫系统对过敏原反应过度而引起的。
通过雪莱Danzy
如果你要从一个城市搬到另一个城市,多带一些纸巾,因为这是真的:季节性过敏可能会在你搬家时爆发,暴露在新的过敏原中。
通过约翰Perritano
一项新的小型研究发现,当你应对季节性过敏时,你的身体可能会有更多的问题,而不仅仅是眼睛瘙痒和流鼻涕。
通过凯特创作
患有非乳糜泻小麦敏感性的人肠道屏障较弱,导致全身免疫反应,而非麸质蛋白可能是罪魁祸首。
通过Jesslyn盾牌
虽然科学家们知道出生季节会影响人们的过敏风险,但他们不知道为什么会发生这种情况。一项研究让我们更近了一步。
通过尼科尔Bazemore
在美国,慢性疾病的第六大原因仍然很难弄清楚。
通过约翰·多诺万
人体需要水才能茁壮成长,所以怎么会有人对水过敏呢?18新利最新登入想想一个奇怪的案例,一个青少年在游泳后爆发了荨麻疹。
通过劳里·l·德芙
血液每时每刻都在你体内流动,这种赋予生命的物质可能是一种过敏原,这似乎是不可想象的。对一些人来说,这不是奇怪的科学——这是现实。
通过劳里·l·德芙
像眼睛发痒、流泪这样的过敏症状处理起来一点也不好玩。你的某些行为模式会导致你自己的痛苦吗?
通过劳里·l·德芙
美国小麦产业应该为无麸质热潮负责吗?不要相信炒作,麸质可能不是你想的那样的问题。
通过小鹿斑比特纳
过敏有时会危及生命,有时只是不方便,它们永远不会在人气竞赛中获胜。虽然我们无法消除它们,但我们可以通过一个简单的家庭技巧来减少它们:手洗盘子!
通过凯伦·柯克帕特里克
一些反对小麦运动的人说,这种谷物含有使人上瘾的化合物。但这是真的吗?
通过艾莉森·库珀
学习如何在旅18新利最新登入行中控制过敏症状。旅行中不再打喷嚏、流眼泪和流鼻涕了!
通过罗布·丹诺夫博士